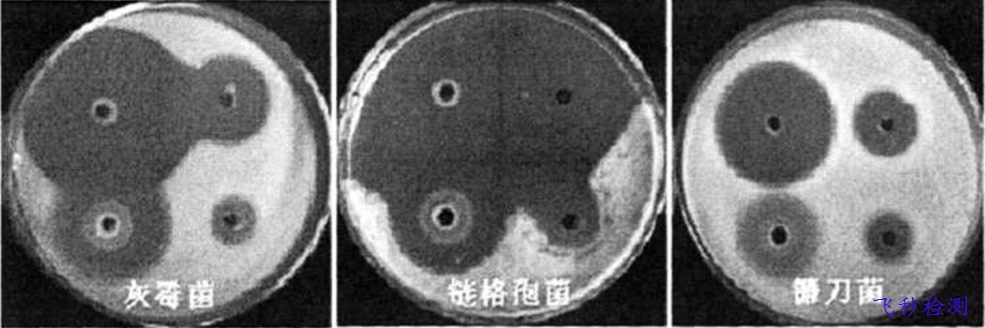
消毒液成分分析檢測

一、含氯消毒液的檢測:
面對疫情,近日隨著各企業單位開始陸續復工,消毒劑作為大家常用的防疫用品被廣泛使用。生活中常用的含氯消毒劑有液氯、漂白粉、三合二、漂白粉精、氯化磷酸三鈉,以及二氯異氰尿酸鈉、三氯異氰尿酸等。
含氯消毒劑是指溶于水產生具有殺微生物活性的次氯酸的消毒劑,其殺微生物有效成分常以有效氯表示。次氯酸分子量小,易擴散到細菌表面并穿透細胞膜進入菌體內,使菌體蛋白氧化導致細菌死亡。含氯消毒劑可殺滅各種微生物,包括細菌繁殖體、病毒、真菌、結核桿菌和抗力最強的細菌芽胞。這類消毒劑包括無機氯化合物(如次氯酸鈉、次氯酸鈣、氯化磷酸三鈉)、有機氯化合物(如二氯異氰尿酸鈉、三氯異氰尿酸、氯銨T等)。無機氯性質不穩定,易受光、熱和潮濕的影響,喪失其有效成分,有機氯則相對穩定,但是溶于水之后均不穩定。

那么該如何檢測產品中的有效效氯含量呢?可用如下方法測得:
對于液體含氯消毒劑,可以取一定體積的產品至容量瓶中,用水定容;對于固體含氯消毒劑,則精密稱取一定質量的產品用水溶解,轉移至容量瓶,用水定容。
向碘量瓶中加入硫酸、碘化鉀及配置好的上述含氯消毒產品,混勻并用水液封,于暗處放置5min,加入淀粉指示劑,用硫代硫酸鈉滴定至藍色消失即可測得產品中的有效率含量。
二、含雙胍消毒液的檢測
雙胍類物質在全球應用已有半個世紀。作為消毒防腐劑的雙胍類大致分為三類:烷基雙胍、芳基雙胍、聚合雙胍。其中烷基雙胍具有抗菌、抗糖尿病等多種生物活性,二甲雙胍metformin就是一種有效的降血糖藥物。芳基雙胍氯己定是用在漱口水中的主要殺菌劑。聚合雙胍是一種新型環保型的消毒防腐劑,主要成分為鹽酸聚六亞甲基雙胍,其雙胍中的甲基胍具有很高的活性,容易被細菌、病毒所吸附,破壞其正常的物質和能量代謝,從而抑制了細菌病毒的分裂功能,使細菌病毒喪失繁殖能力,而且聚合物的形成堵塞了微生物的呼吸通工業防霉防菌產業技術創新戰略聯盟道,使微生物窒息而死。聚合雙胍殺菌效力大大高于其它胍類,而且細菌不易產生耐藥性。聚合雙胍類消毒防腐劑廣譜抗菌、低濃度高效能的特點,在醫用、隱形眼鏡護理液、食品、飲料和家用產品中常用作消毒劑和防腐劑。
 雙胍類是一種廣譜、速效殺菌劑,聚合雙胍類具有很高的活性,在不同的濃度下有防腐殺菌作用且毒性低。以比較常見的聚合雙胍——聚六亞甲基雙胍為例,其水溶液有效成分20%,有效成分對熱穩定且無揮發性。
雙胍類是一種廣譜、速效殺菌劑,聚合雙胍類具有很高的活性,在不同的濃度下有防腐殺菌作用且毒性低。以比較常見的聚合雙胍——聚六亞甲基雙胍為例,其水溶液有效成分20%,有效成分對熱穩定且無揮發性。
利用懸液定量殺菌或載體定量殺菌試驗對雙胍類消毒防腐劑的殺菌效果進行測定,國內己有多篇論文報道。
有用懸液定量殺菌試驗,以含13500mg/L聚合雙胍消毒液,篩選出的中和劑為0.3%卵磷脂、2.O%吐溫一80、0.5%硫代硫酸鈉、0.1%組氨酸、1.0%皂基的胰蛋白胨生理鹽水溶液;對懸液內大腸桿菌和金黃色葡萄球菌作用15min,殺滅對數值>5.00;聚合雙胍消毒液含量13500mgf/L作用15min,對木質物體表面的平均殺滅數值>3.40。有用載體定量殺菌試驗,對以聚合雙胍為主要殺菌成分的某消毒波進行殺菌效果研究,結果是以含2000mg/L聚舍取胍消毒液作用3min,對載體上金黃色葡萄球菌和大腸樸苗平均殺滅率這99.99%以上:用3750mg/L該消毒液作用5min.對白色念珠菌殺滅率選99.99%以上。
運用抑菌環法測試聚合雙胍對葡萄灰霉病菌、葡萄黑斑病菌、甜瓜枯萎病菌鐮刀菌等幾種比較有代表性的菌種的殺菌情況,測試結果所示:
不同濃度稀釋倍數條件下聚合雙胍殺菌液對三種菌的抑菌效果比較

聚合雙胍對果蔬病原真菌的抑菌效果
三、含雙胍消毒液的檢測
過氧乙酸是一種高效廣譜消毒劑,溫度在0℃以下,過氧乙酸仍可保持活性,被用于噴霧消毒,廣泛地使用在室內空氣、居室表面與家具表面等處的消毒。衛生部《消毒技術規范》(2002)規定消毒液中過氧乙酸含量的檢驗方法是化學法,化學法的缺點是操作復雜,時間長,抗干擾性差,影響因素較多,另外化學滴定法的終點觀察不穩定,影響最終結果。我們利用氣相色譜法對消毒液中過氧乙酸的測定進行了研究。
1.1色譜條件
色譜柱FFAP以1:5涂于填充有ChromosorbW-AWDMCS(60~80目)的內徑4mm、長2m的不銹鋼色譜柱上,柱溫200℃,汽化室溫260℃,檢測室溫260℃,載氣氮氣流速40mL/min,火焰離子化檢測器(F1D)檢測,過氧乙酸出峰時間為55s。
1.2過氧乙酸標準工作液的配制
過氧乙酸臨用前配制。用碘量法標定20%過氧乙酸的含量,然后精密移取20%過氧乙酸0.5、2.5、5.0、10.0、15.0mL,用水稀釋至100mL容量瓶中,配成0.1%,0.5%,1.0%,2.0%,3.0%過氧乙酸標準液,分別在色譜儀上進樣1uL,重復6次,計算回歸方程、相關系數與相對標準差。
1.3工作曲線法
用1.2中配制的溶液以峰高為縱坐標,以過氧乙酸的含量為橫坐標繪制工作曲線,求回歸方程。
1.4樣品測定準確吸取樣品溶液1uL進樣,經過測定后,從工作曲線上查出樣液中過氧乙酸的含量或通過回歸方程計算出溶液中過氧乙酸的含量。
2結果
2.1檢出限、精密度與線性范圍以3倍噪聲水平計算檢出限為0.001%。用1.2中配制的溶液,過氧乙酸含量在0.1%,0.5%,1.0%,2.0%,3.0%(n=6)時,RSD分別為1.0%,2.3%,1.5%,2.93%,2.29%。本方法在過氧乙酸濃度為0.01%~25%時成線性,回歸方程為y=11.815x+0.9048,相關系數為0.9991。2.2回收率實驗以含有過氧乙酸的消毒液為本底,分別加入標準溶液,加入0.1%,0.5%,1.0%過氧乙酸測其回收率,其均值分別為93%,102%和101%,平均為98.3%(表1)

2.4樣品測定結果利用本方法對6個消毒液樣品進行了測定,其過氧乙酸含量分別為16.4%,15.5%,0.31%,0.55%,0.15%,1.12%。
本法選擇性強,靈敏度高,操作簡單準確,檢出限為0.001%,樣品回收率為93%~102%,變異系數小于2.93%。樣品不經預處理可直接進樣測定。此方法可廣泛應用于消毒液中過氧乙酸含量的檢測。